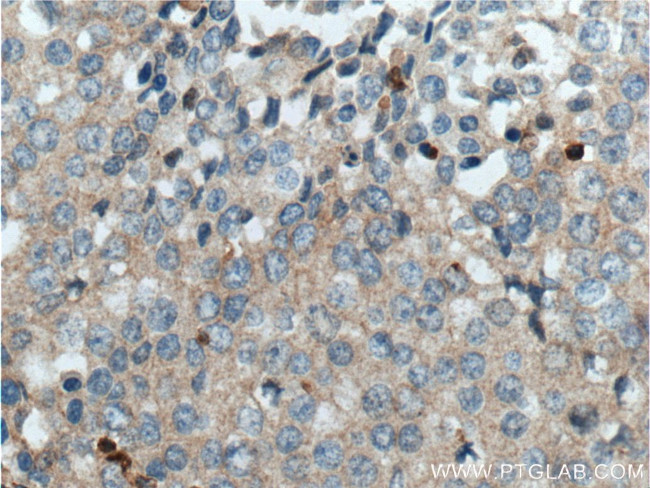
Integrin beta-1 Antibody in Immunohistochemistry (Paraffin) (IHC (P))

Search
Proteintech
Integrin beta-1 Polyclonal Antibody
{{$productOrderCtrl.translations['antibody.pdp.commerceCard.promotion.promotions']}}
{{$productOrderCtrl.translations['antibody.pdp.commerceCard.promotion.viewpromo']}}
{{$productOrderCtrl.translations['antibody.pdp.commerceCard.promotion.promocode']}}: {{promo.promoCode}} {{promo.promoTitle}} {{promo.promoDescription}}. {{$productOrderCtrl.translations['antibody.pdp.commerceCard.promotion.learnmore']}}
产品信息
26918-1-AP
种属反应
已发表种属
宿主/亚型
分类
类型
抗原
偶联物
形式
浓度
规格
纯化类型
保存液
内含物
保存条件
运输条件
产品详细信息
Immunogen sequence: KLLMIIHDR REFAKFEKEK MNAKWDTGEN PIYKSAVTTV VNPKYEGK (752-798 aa encoded by BC020057)
靶标信息
CD29, also known as ITGB1 or Integrin Subunit Beta 1, is a 110 kDa cell surface glycoprotein widely expressed by various cells, including all leukocytes. It forms non-covalently linked heterodimers with at least six different alpha integrins (CD49a-f), creating VLA-1 through VLA-6 complexes, as well as with CD51. These alpha-beta integrin heterodimers mediate a range of cellular responses, including adhesion, trafficking, proliferation, and differentiation. CD29-containing integrins bind to extracellular matrix proteins such as collagen, laminin, fibronectin, and vitronectin. Some integrins also interact with cellular receptors like VCAM-1 and MadCAM-1. CD29 plays a crucial role in immune cell trafficking from blood to tissue, particularly during leukocyte emigration and extravascular migration. It is involved in regulating tissue damage and disease symptoms related to inflammatory bowel disease. In the presence of anti-tumor drugs, decreased expression of ITGB1 correlates with multidrug resistance in tumor cells. ITGB1-dependent mechanisms enhance cytokine secretion in human airway smooth muscle in response to IL-1beta, facilitated by fibronectin and type I collagen. More than eight beta subunits with numerous splice variant isoforms have been identified in mammals, including two major forms: beta1A and beta1D. Beta1A is present in all tissues except cardiac and skeletal muscle, which express the beta1D variant.
仅用于科研。不用于诊断过程。未经明确授权不得转售。
生物信息学
蛋白别名: CD29; Fibronectin receptor subunit beta; Glycoprotein IIa; GPIIA; integrin beta 1; Integrin beta-1; integrin beta-1 subunit (cytoplasmic domain); Integrin beta1; integrin VLA-4 beta subunit; integrin, beta 1 (fibronectin receptor, beta polypeptide, antigen CD29 includes MDF2, MSK12); ITBG1D; unnamed protein product; very late activation protein, beta polypeptide; VLA-4 subunit beta
基因别名: CD29; FNRB; GPIIA; ITGB1; MDF2; MSK12; VLA-BETA; VLAB
UniProt ID: (Human) P05556
Entrez Gene ID: (Human) 3688